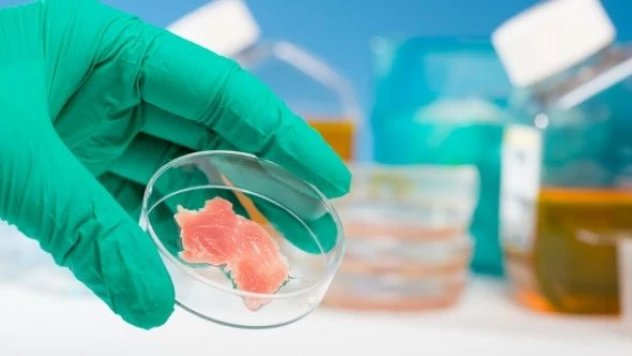
Diyanet'ten o gıdaya onay çıkmadı: Helal gıda olamaz!

Sağlık

Uzmanlar uyardı: Omikron'a yakalanan iki doz aşılılarda görülüyor
Diyanet'ten o gıdaya onay çıkmadı: Helal gıda olamaz!

DSÖ: "Maymun çiçeği salgınının merkez üssü Avrupa"

Maymun çiçeği havalimanında tespit edildi

'Aile diş hekimliği' geliyor

Turgut Özal Tıp Merkezinde yenilenen Pulmoner Rehabilitasyon Merkezi'nin açılışı yapıldı

Yeniçağa Belediye Başkanı Çağlar, Malatya'da karaciğer nakliyle sağlığına kavuştu:

Yeni koronavirüs farelerde ortaya çıktı!

DSÖ: "Maymun çiçeği, yıllardır fark edilmeden yayılmış olabilir"

Felaket geliyorum diyor: maymun çiçeği giderek yayılıyor

Kovid-19'dan 4 kişi hayatını kaybetti

Bill Gates: "Bir biyoterörist tarafından da üretilebilir"

Maymun çiçeği hızla yayılıyor

Bakan Koca'dan Türkiye'de maymun çiçeği vakalarına dair açıklama

Maymun çiçeği için aşı siparişi!

Maymun çiçeği hızla yayılıyor

Kovid-19 vaka sayısı binin altına düştü

Bakan Koca açıkladı : Maymun Çiçeği pandemiye yol açar mı?

Bakan Fahrettin Koca: “Kamuoyu müsterih olmalı”

10 soruda 'maymun çiçeği' hastalığı !

Sağlık Bakanlığı açıkladı: Ülkemizde maymun çiçeği vakası görüldü mü?

Türk Tabipleri Birliği: "Maymun çiçeği, virüslü materyalden insana bulaşabilir"

Yeni pandemi mi geliyor? Maymun çiçeği virüsü yayılıyor

Türkiye'de koronavirüste can kaybı 4'e geriledi!

Kovid-19 vakaları artış gösterdi

Maymun çiçeği virüsü yayılıyor!

SGK fatura ve reçete teslim süresini uzattı!

Erzurumlu erkek hemşire güler yüzüyle hastaların gönlünü kazanıyor

Pandemi geri mi geliyor? 50 ülkede vaka sayısı arttı

5 il iki doz aşılamada yerinde sayıyor!

Dang humması yeniden hortladı!

Ameliyat öncesi PCR testi zorunluluğu kaldırıldı!

Türk bilim insanı 'sinekten' kozmetik hammaddesi üretti

Bilim Kurulu üyesi Prof. Deniz Odabaş: "Kalan kısıtlamalar haziranda kalkabilir!"

DSÖ: "Omikron'un 2 yeni alt varyantı tespit edildi"

DSÖ: Türkiye listenin ilk sırasında!

5 il iki doz aşılamada yerinde sayıyor!

Bill Gates'ten salgın uyarısı: "En kötüsünü henüz görmedik"

Gizemli hepatit can almaya devam ediyor!

5 il için kötiü haber!











